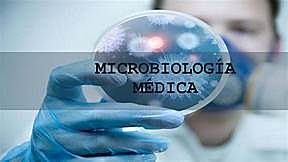
Microbiologia Medica

-
A este personaje se le asocia con la invención del microscopio de una sola lente (simple) y el compuesto ( de dos o mas lentes). Se dice que construyo un instrumento de 9 aumentos, del que aveces se afirma que fue elaborado con la ayuda de su padre.
-
Fue un médico, naturalista, fisiólogo, y literato italiano. Demostró que los insectos no nacen por generación espontánea,1 por lo que se le considera el fundador de la HELMINTOLOGIA (el estudio de los gusanos). Realizó estudios sobre el veneno de las víboras, y escribió observaciones en torno a las víboras.
-
Jugo un papel importante en una revolución científica, En 1665 publicó el libro Micrographía, donde describe 50 observaciones microscópicas con detallados dibujos. Este libro contiene por primera vez la palabra célula y en él se apunta una explicación plausible acerca de los fósiles.
-
Realizó la primera descripción precisa de los glóbulos rojos en 1674 Fue el primero en realizar importantes observaciones con microscopios fabricados por él mismo. Desde 1674 hasta su muerte, numerosos descubrimientos. Fue el precursor de la biología experimental, la biología celular y la micro biología.
-
Acaba con la idea de la generación espontánea (Experimento de Redi). Usos unos botes de cristal con trozos de carne, dichos botes, la tapa con unas gasas que permiten el paso del aire, pero nada más que los "animáculos" en estos trozos de carne. La solución está en las larvas que son depositadas por las moscas que se posan en la carne, en los botes sin tapar, y se hizo posible la aparición de esos "animáculos"
-
El problema de la regeneración espontánea de partes del cuerpo de anfibios y de reptiles, aunque no pudo llegar a resultados satisfactorios, sobre todo no pudo explicar el por qué no sucedió lo mismo en el ser humano y en otros animales.
-
Fue un afamado investigador, médico rural y poeta, cuyo descubrimiento de la vacuna antivariólica (Viruela) tuvo trascendencia definitoria para combatir la viruela. En el campo de la zoología, fue la primera persona en describir el parasitismo del cuco.
-
Él descubrió que la "muscardina" o "mal del segno" --una enfermedad del gusano de seda-- era causada por un muy pequeño organismo parasítico. Bassi avanzó la idea de que no sólo las enfermedades de los animales (insectos), sino también enfermedades humanas como la sífilis, el sarampión y la peste eran causadas por microorganismos vivientes.Hizo un gran descubrimiento en la bacteriología moderna.
-
A través de experimentos refutó definitivamente la teoría de la generación espontánea y desarrolló la teoría germinal de las enfermedades infecciosas.y el desarrollo de las invenciones tan importantes como el desarrollo de las vacunas, los antibióticos, la esterilización y la higiene como métodos efectivos de cura y prevención Contra la propagación de las enfermedades infecciosas.
-
Berkeley es considerado padre de la Micología británica; llegando a describir muchísimas especies. Su herbario de cerca de 10 000 especies de hongos (con alrededor de 5000 que describe) se conservan en las colecciones de los Reales Jardines Botánicos de Kew.
-
Describió por primera vez el componente micótico de las lesiones de la pitiriasis versicolor.La pitiriasis versicolor es una enfermedad infecciosa de la piel, la causada por los hongos del género Malassezia, la agrupa las especies de levaduras dimórficas lipofílicas que forman parte de la flora cutánea normal
-
Es reconocido como el creador de los procedimientos antisépticos. Semmelweis es llamado el "salvador de madres" pues descubrió que la incidencia de la sepsis puerperal o fiebre puerperal. Podía ser disminuida drásticamente usando desinfección de las manos en las clínicas obstétricas.
-
Fue un biólogo y médico suizo. Aisló varias moléculas ricas en fosfatos, a las cuales llamó nucleínas (actualmente ácidos nucleicos), a partir del núcleo de los glóbulos blancos en 1869, y así preparó el camino para su identificación como los portadores de la información hereditaria, el ADN.
-
Propuso la clasificación de las bacterias: género, especie y variedades. Describió otros microorganismos patógenos transmitidos por agua contaminada.
-
En 1877 se inventó la placa de petri. Esto se utiliza en los laboratorios principalmente para el cultivo de microorganismos, y se puede utilizar para el cultivo de microorganismos.
-
Se hizo famoso por descubrir el bacilo de la tuberculosis en 1882,así como el bacilo del cólera.Es considerado el fundador de la bacteriología.
-
Fue un bacteriólogo danés que desarrolló la tinción de Gram, de amplio uso en microbiología.Se utiliza tanto para poder referirse a la morfología celular bacteriana, como para poder realizar una primera aproximación a la diferenciación bacteriana, teniendo en cuenta las bacterias gram positivas y visuales. Color morado, y bacterias gram negativas.
-
Médico bacteriólogo alemán. En 1894 describió el fenómeno de la bacteriolisis, que tuvo gran trascendencia al facilitar el diagnóstico del cólera. Su nombre ha quedado ligado al bacilo que descubrió en 1892, agente causal de la gripe. Pfeiffer descubrió además las endotoxinas y creó, junto a Kolle, los métodos para la inmunización frente a la fiebre tifoidea y a la peste.
-
Vinogradski es conocido por descubrir la quimioautotrofía, el proceso por el cual los organismos derivan energía de un número de compuestos diferentes inorgánicos, obteniendo carbono en la forma de dióxido de carbono.
-
Fue un científico británico famoso por ser el primero en observar los efectos antibióticos de la penicilina, obtenida a partir del hongo Penicillium notatum. También descubrió la enzima antimicrobiana lisozima.
-
El ácido desoxirribonucleico, abreviado como ADN, es un ácido nucleico que contiene las instrucciones genéticas usadas en el desarrollo y el funcionamiento de todos los virus y el responsable de su transmisión hereditaria.
-
El ácido ribonucleico (ARN o ARN) es un ácido nucleico formado por una cadena de ribonucleótidos. Está presente tanto en las células procariotas como en las eucariotas, y es el único material genético de virus (virus ARN).
-
Durante el siglo XX la microbio logia experimento un rápido desarrollo en dos direcciones distintas pero complementarias, una básica y otra aplicada.
-
Se basaen la produccion de mediacamntos, productos quimicos e industriales, alimentos y bebidas. Destacando sus amplias aportaciones de todos estos campos centrales en el desarrollo de nuestra sociedad.
-
Es la ciencia que estudia el diagnostico de las enfermedades infecciosas por medio del aislamiento de los agentes infecciosos, así como la demostración de la respuesta inmunologica en el paciente.
-
Estudia a los microorganismos benéficos y malignos que interactuan en la tierra con ayuda de estos conocimientos podemos mejorar la "tierra de cultivo" es decir hacerla MAS FÉRTIL, obteniendo productos de calidad mejorada.
-
Estudia la estructura y la vida de los microorganismos que viven en los mares, su integración en los ciclos de transformación materia / energía y su relación con los demás animales y plantas que comparten con ellos el hábitat marino.
-
Estudio de la función y diversidad de los microbios en sus entornos naturales. Incluye la ecología microbiana, geomicrobiologia, la diversidad microbiana y la bioremediacion.
-
Estudio del papel y función de los microbios en la medicina veterinaria.
-
Control de los diferentes procesos y métodos para la preparación de los alimentos con la finalidad de prevenir alteraciones, fundamentalmente de origen microbiano que pueden producir sabores anormales.
Looking for a timeline maker?
Create timelines for projects, roadmaps, history, lessons, legal cases, and stories with Timetoast. Timetoast is a timeline maker for work, school, research, and stories.